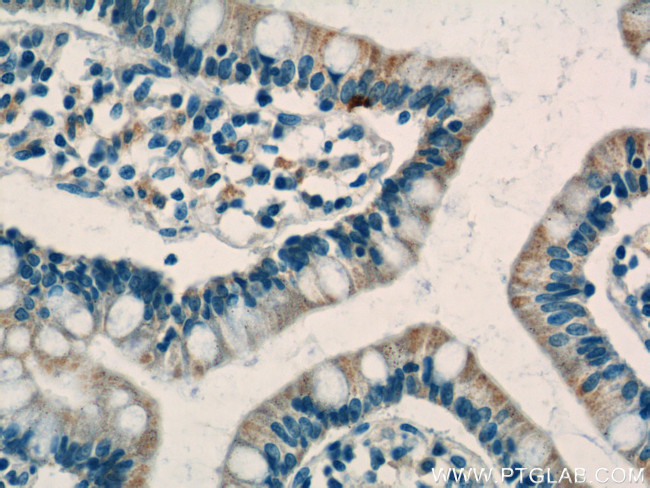
C1QTNF3 Antibody in Immunohistochemistry (Paraffin) (IHC (P))

Search
Proteintech
C1QTNF3 Polyclonal Antibody
{{$productOrderCtrl.translations['antibody.pdp.commerceCard.promotion.promotions']}}
{{$productOrderCtrl.translations['antibody.pdp.commerceCard.promotion.viewpromo']}}
{{$productOrderCtrl.translations['antibody.pdp.commerceCard.promotion.promocode']}}: {{promo.promoCode}} {{promo.promoTitle}} {{promo.promoDescription}}. {{$productOrderCtrl.translations['antibody.pdp.commerceCard.promotion.learnmore']}}
产品信息
11414-1-AP
种属反应
宿主/亚型
分类
类型
抗原
偶联物
形式
浓度
规格
纯化类型
保存液
内含物
保存条件
运输条件
产品详细信息
Immunogen sequence: IAFMASLAT HFSNQNSGII FSSVETNIGN FFDVMTGRFG APVSGVYFFT FSMMKHEDVE EVYVYLMHNG NTVFSMYSYE MKGKSDTSSN HAVLKLAEGD EVWLRMGNGA LHGDHQRFST FAGFLLFETK (118-246 aa encoded by BC016021)
靶标信息
Adipose tissue of an organism plays a major role in regulating physiologic and pathologic processes such as metabolism and immunity by producing and secreting a variety of bioactive molecules termed adipokines. One highly conserved family of adipokines is adiponectin/ACRP30 and its structural and functional paralogs, the C1q/tumor necrosis factor-alpha-related proteins (CTRPs) 1-7. Unlike adiponectin, which is expressed exclusively by differentiated adipocytes, the CTRPs are expressed in a wide variety of tissues. An analysis of the crystal structure of adiponectin revealed a structural and evolutionary link between TNF and C1q-containing proteins, suggesting that these proteins arose from a common ancestral innate immunity gene. Multiple isoforms of human CTRP3 have been reported. It has been suggested that CTRP3 may play a role in skeletal development.
仅用于科研。不用于诊断过程。未经明确授权不得转售。
生物信息学
蛋白别名: C1q and tumor necrosis factor related protein 3; cartducin; cartonectin; Collagenous repeat-containing sequence 26 kDa protein; collagenous repeat-containing sequence of 26-kDa; Complement C1q tumor necrosis factor-related protein 3; CORS26; Secretory protein CORS26; unnamed protein product
基因别名: 2310005P21Rik; C1ATNF3; C1QTNF3; CORCS; CORS; CORS-26; CORS26; CTRP3; UNQ753/PRO1484
UniProt ID: (Human) Q9BXJ4, (Mouse) Q9ES30
Entrez Gene ID: (Human) 114899, (Rat) 294806, (Mouse) 81799